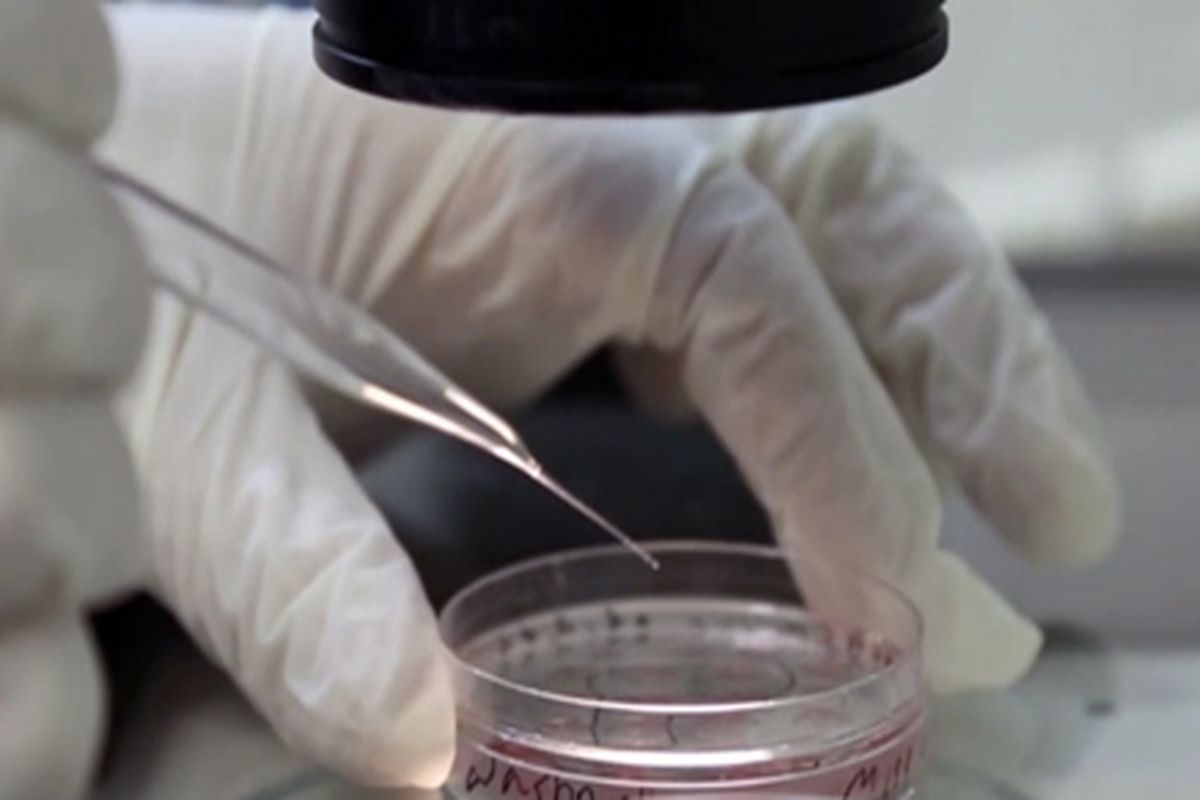

انجام بیش از ۳۰۰ عمل پیوند سلول های بنیادی خونساز در مشهد
به گزارش خبرگزاری برنا از مشهد، علی قاسمی با اشاره به اینکه این مرکز در سال 91 راه اندازی شد و جزو 5 مرکز پیوند سلول های بنیادی خون ساز در کشور محسوب می شد، خاطر نشان کرد: این مرکز در حوزه پیوند مغز استخوان کودکان نیز دومین مرکز پیوند در کل کشور محسوب می شود.
فوق تخصص خون و انکولوژی کودکان و پیوند سلول های بنیادی ابراز کرد: تاکنون 21 نوع بیماری در دانشگاه علوم پزشکی مشهد با پیوند مغز استخوان درمان شده اند.
دکتر قاسمی با بیان اینکه از لحاظ تنوع و نوع بیمارانی که پیوند شده اند در کشور رتبه سوم به مرکز پیوند مغز استخوان دانشگاه علوم پزشکی مشهد اختصاص دارد، تصریح کرد: انواع پیوند آلوژنیک و اتولوگ در دانشگاه علوم پزشکی مشهد صورت گرفته است که این امر موجب نجات جان بسیاری از بیماران شده است.
وی با اشاره به اینکه پیوند مغز استخوان از خود فرد بیمار، خواهر یا برادر، پدر و مادر، اقوام درجه دوم، بند ناف و بانک سلول های بنیادی ایران در بیمارستان منتصریه مشهد انجام شده است گفت: بهترین نوع پیوند از خواهر یا برادر فرد بیمار است که می توان نتایج خوبی را از آن انتظار داشت.
رئیس بخش پیوند سلول های بنیادی دانشگاه علوم پزشکی مشهد ابراز کرد: در صورت امکان افزایش فضای فیزیکی بخش، این مرکز با نیروی انسانی کافی که در اختیار دارد، می تواند به بیماران بیشتری خدمات درمانی ارایه کند.
وی تاکید کرد: 68 درصد بیماران پیوند مغز استخوان شده در دانشگاه علوم پزشکی طول عمر بالای ۵ سال عاری از بیماری داشته اند که این امر نشان دهنده موفقیت پیوندهای انجام شده است.












































